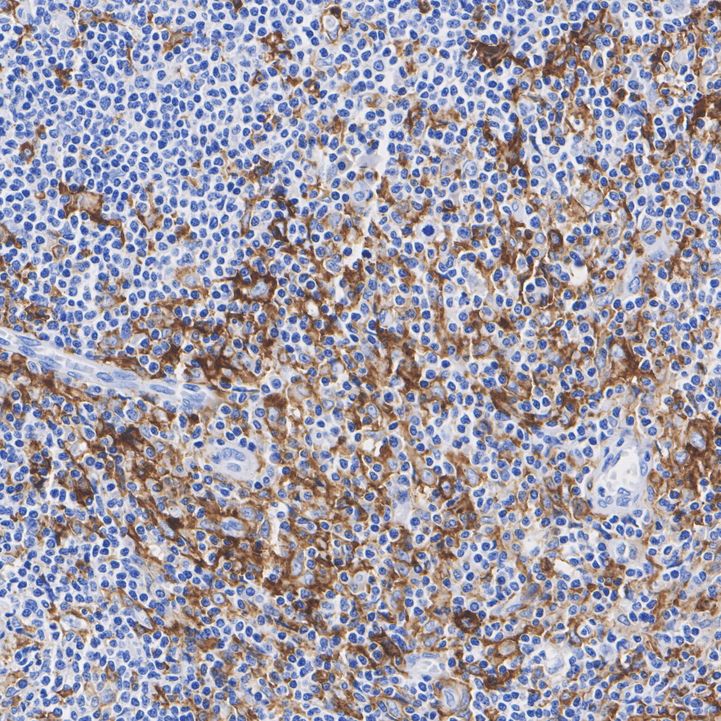

CD11c Recombinant Antibody [SI19-06] - Mouse IgG1 (Chimeric) - BSA and Azide free
Catalog# HA610361
CD11c Recombinant Antibody [SI19-06] - Mouse IgG1 (Chimeric) - BSA and Azide free
Application
-
IF-Tissue
-
IHC-P
Reactivity
-
Human
With BSA and Azide
-
HA601545
含抗保成分
Conjugation
-
unconjugated